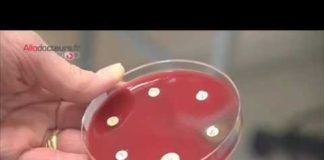
La chasse à l’helicobacter pylori, cause de certains maux d’estomac Maux-destomac-la-chasse-a-lHelicobacter-pylori-Allo-Docteurs

Certaines bactéries ne résistent pas à l’ail
Une nouvelle étude de l’Université de Copenhague, publiée dans « Scientific Reports », suggère que l’ail pourrait aider à lutter contre des bactéries résistantes affectant notamment les malades de la mucoviscidose.
Pour aller plus loin
Un nid à bactéries, la barbe ?
Pour les hommes, depuis quelques années, difficile d'échapper à la barbe. Mais que penser de l'hygiène de cette mode...
Le microbiote : des bonnes bactéries pour toute la vie !
Les mille premiers jours de la vie façonnent un acteur central pour la santé immunitaire : le microbiote intestinal....
Où sont les bactéries et comment s’en protéger ?
Notre cuisine est un véritable nid à bactéries ! Éponge, réfrigérateur, four : où se cachent-elles ? Où sont-elles...
Les piscines publiques sont-elles dangereuses pour la santé ?
Les bassins regorgeraient de bactéries en tout genre, potentiellement dangereuses pour la santé. Et ce malgré la présence de...
Pourquoi certaines souches de listeria sont-elle hypervirulentes ?
Certaines souches de la bactérie causant la listériose manipulent le système immunitaire, ce qui augmente leur capacité à infecter...
Pourquoi la bactérie E.coli est-elle dangereuse ?
Depuis le début du mois de février, les cas d’infection grave liés à des bactéries E.coli sont en augmentation....
Les coraux rendus plus résistants à la chaleur grâce à des bactéries
Les colonies de corail sont vulnérables aux chocs thermiques. Mais un cocktail de bactéries aiderait le corail à survivre...
Comment dépister l’helicobacter pylori, responsable des ulcères ?
Pour dépister un ulcère gastro-duodénal, il est possible de réaliser une fibroscopie. Un examen de seulement quelques minutes, qui...
Respirer et jardiner sur Mars, grâce à des cyanobactéries
Un système de support de vie basé sur les ressources martiennes et des organismes vivants parmi les plus anciens...
La chasse à l’helicobacter pylori, cause de certains maux d’estomac
Pour bien soigner les maux d'estomac, mieux vaut savoir à qui l'on a affaire. Dans les laboratoires d'analyse bactériologique,...
Articles dans la même catégorie
Tout savoir sur la vaginoplastie
La vaginoplastie est une intervention chirurgicale qui vise à réduire le diamètre du vagin et à renforcer les muscles du périnée. Elle est généralement réalisée pour des raisons de...
Quelles alternatives pour remplacer le sel ?
Le sel est un ingrédient omniprésent dans notre alimentation quotidienne, mais sa consommation excessive peut avoir des effets néfastes sur notre santé. Pourtant, il existe de nombreuses alternatives savoureuses...
Les facteurs déclenchants de la sclérose en plaques
La sclérose en plaques (SEP) est une maladie neurologique chronique qui affecte le système nerveux central, principalement le cerveau et la moelle épinière.
Cette affection est caractérisée par une démyélinisation...
Portrait d’une asexuelle : vivre sans relation sexuelle
Peut-on se passer de sexe ? L'absence de relations sexuelles est souvent vue comme problématique. Mais l'est-elle vraiment ? Pour le savoir, nous avons rencontré une asexuelle.
L’endométriose aggravée par les traitements contre la fertitilé ?
Les femmes atteintes d’endométriose non diagnostiquées et ayant recours à des traitements de fertilité verraient leur maladie progresser, selon une nouvelle étude scientifique.
Enfants hypersensibles
Hypersensibilité des enfants : c’est dans le cerveau que ça se joue ! Les hypersensibles représentent 15 à 20% de la population, et les enfants demeurent particulièrement touchés… Souvent...
Spondylarthrite : comment la traiter ?
Mal de dos : comment améliorer le diagnostic de la spondylarthrite ?
Comment bien choisir ses petits pots pour bébé ?
Même si en France, depuis une dizaine d'années, l'alimentation infantile industrielle est en recul, certaines familles en manque de temps pour planifier les menus, faire les courses et cuisiner......
Boissons de l’apéro : que contiennent-elles vraiment ?
L'alcool, très calorique, peut avoir des conséquences nutritionnelles importantes et contribuer à la prise de poids. Alors quelles boissons privilégier ? Les réponses de notre diététicienne, Angélique Houlbert. ...
Le cycle menstruel influence-t-il notre libido ?
A quel moment de leur cycle les femmes ont-elles le plus envie de sexe ? Y a-t-il un pic de la libido pendant les règles ? Quel est le...